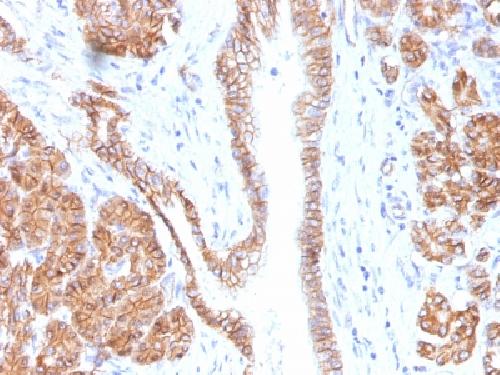
产品细节图片2

相关产品推荐更多 >

Mouse Hoxc4 Antibody (Center) 抗体,orb1934141,Biorbyt
¥7293
SOD1 Antibody - C-terminal region : Biotin 抗体,orb2096509,Biorbyt
¥8216
TNFAIP3 Antibody : FITC 抗体,orb2096199,Biorbyt
¥8216
SARDH Antibody - middle region : Biotin 抗体,orb2122357,Biorbyt
¥7345
IGSF22 Antibody - N-terminal region : FITC 抗体,orb2086194,Biorbyt
¥8216
万千商家帮你免费找货
0 人在求购买到急需产品
- 详细信息
- 文献和实验
- 技术资料
- 抗体名:
Catenin, beta (p120) Antibody抗体
- 抗体英文名:
Catenin, beta (p120) Antibody
- 靶点:
CTNNB1
- 应用范围:
IHC
- 宿主:
Mouse
- 适应物种:
Human, Mouse, Rat
- 保质期:
6-12个月
- 抗原来源:
详询
- 目录编号:
orb388019
- 级别:
科研级
- 库存:
88
- 供应商:
biorbyt
- 标记物:
Unconjugated
- 克隆性:
Monoclonal
- 保存条件:
参考说明书
- 形态:
200ug/ml of Ab purified from Bioreactor Concentrate by Protein A/G. Prepared in 10mM PBS with 0.05% rAlbumin & 0.05% azide. Also available WITHOUT rAlbumin & azide at 1.0mg/ml.
- 亚型:
IgG1
- 免疫原:
Recombinant human beta-Catenin (p120) protein fragment
- 规格:
20 ug
别名:Cadherin associated protein, beta 1 88kDa, Catenin beta-1, CATNB, CHBCAT, CTNNB1
免疫原:Recombinant human beta-Catenin (p120) protein fragment
克隆性:CTNNB1/1508
分子量:92kDa
应用稀释比例:FACS: 0.5-1 μg/million cells, IF/ICC: 1-2 μg/ml, WB: 0.5-1 μg/ml, IHC-P: 1-2 μg/ml
应用注释:Catenin, beta (p120)
纯化:Protein G
保存说明:Maintain refrigerated at 2-8°C for up to 2 weeks. For long term storage store at -20°C in small aliquots to prevent freeze-thaw cycles.
UniProt ID:P35222
Note:For research use only.

风险提示:丁香通仅作为第三方平台,为商家信息发布提供平台空间。用户咨询产品时请注意保护个人信息及财产安全,合理判断,谨慎选购商品,商家和用户对交易行为负责。对于医疗器械类产品,请先查证核实企业经营资质和医疗器械产品注册证情况。
 文献和实验
文献和实验liqiuling 怎么才能获取beta catenin的基因? chuckdouble pubmed里面有Nucleotide.到那里找. liqiuling 不太会看,而且合成的话,很贵,想知道如果想获得别人的惠赠,该怎样做?哪位大侠支个招?不胜感激! lmnsmu 在NCBI的核酸库中找到其序列,然后设计引物,通过RT-PCR扩增获得该基因
familar 小妹困惑,在此请教大师! 做了几次beta-catenin的表达(western),都没做出来,目的蛋白的分子量是92,可是,做出来的印记总是在下方,明显的不是目的蛋白的位置。我师兄说,做beta-catenin要提核蛋白才能做出来,可我之前也有做出来过的!请教各位有经验的同志,这样的现象是何解? woxingwosu 不一定要提核蛋白才能出来。b-catenin在核内核外都有分布。应该
【求助】细胞里的beta catenin 好检测吗?? 用 western blot
antonio2001 细胞里的beta catenin 好检测吗?? 用 western blot 和免疫细胞化学 ?? 2008851029 细胞里的beta-actin非常好检测(我用的是ST的抗体) littlebee83325 什么细胞呢?胞浆蛋白么? magichunter beta catenin 好检测,细胞全蛋白裂解液上样20uL(15
 技术资料
技术资料暂无技术资料 索取技术资料





